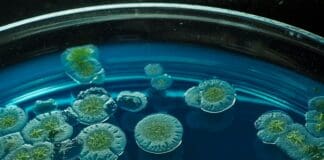
רפואה מיקרוביאלית: כיצד חיידקי המעי עשויים לעצור את הגאוט לפני הופעתה

Home Blog
פלטפורמת מסרים ארגונית הפכה לשער לפריצות סייבר
חברת Nikkei Inc., ארגון החדשות הכלכליות הגדול ביותר ביפן ובעלת ה-Financial Times, חשפה כי האקרים הצליחו לגשת לרשתותיה דרך חשבון Slack של אחד העובדים,...
נינטנדו מנצחת שוב בבית המשפט במאבק נגד פיראטיות משחקים
חברת נינטנדו רשמה ניצחון נוסף במסע המתמשך שלה נגד פיראטיות משחקים, לאחר שבית משפט בארצות הברית פסק לטובתה בתביעה נגד סטרימר שהואשם בהזרמה בלתי...
בינה מלאכותית שלומדת מהדמיון במקום מניסוי וטעייה
מזה זמן רב שבינה מלאכותית מצטיינת במשחקים ובסימולציות פשוטות, אך רוב המערכות עדיין נשענות על מיליוני ניסיונות וטעויות כדי ללמוד. גישה זו, אף שהיא...
פיקסלים בקנה מידה של העין: המסך שמגיע למקסימום רזולוציה אנושית
צוות מדענים משוודיה פיתח טכנולוגיית מסך שמגיעה לרזולוציה הגבוהה ביותר שהעין האנושית מסוגלת לתפוס, ופותחת אפשרויות להצגת תצוגות אולטרה-ריאליסטיות במציאות מדומה ומציאות רבודה. פריצת...
בינה מלאכותית על השדה: רובוטים חקלאיים ללא נהג
מגיע דור חדש של רכבים חקלאיים אוטונומיים– כאלה שנועדו לבצע עבודות שדה בדיוק ובגמישות של עובד אנושי, אך ללא נהג אנושי כלל. בכנס FIRA...
שמירה על קור רוח: פתרון תלת-שכבתי להתחממות יתר של מיקרו-שבבים
ככל שהאלקטרוניקה ממשיכה להתכווץ ולהתחזק, ניהול החום הפך לאתגר קריטי. ככל שהמעגלים צפופים יותר, כך נוצר חום רב יותר בשטח מצומצם — מה שמעלה...
רפואה מיקרוביאלית: כיצד חיידקי המעי עשויים לעצור את הגאוט לפני הופעתה
במשך מאות שנים קושרה מחלת הגאוט (שיגדון) עם כאבי מפרקים. בפועל, מדובר בתוצאה של שנים של רמות חומצת שתן גבוהות – מצב הידוע כהיפראוריצמיה...
הגנה דינמית: מתכת חכמה סופגת אנרגיה לפי עוצמת הפגיעה
חומר מתכתי חדש, שהודפס בתלת־ממד ותוכנן להתפתל בעת פגיעה, עשוי לסלול את הדרך לדור הבא של מערכות הגנה מתקדמות לרכבים ולמטוסים. החדשנות, שפותחה בשיתוף...
למחזר את הבלתי ניתן למחזור: טפלון מקבל חיים חדשים
שיטה חדשה למחזור כימי עשויה סוף־סוף להציע פתרון בר־קיימא לאחד מהפלסטיקים העמידים ביותר שנוצרו אי פעם. חוקרים מאוניברסיטת ברמינגהם ואוניברסיטת ניוקאסל פיתחו תהליך פשוט...
מרכזי נתונים מהירים וחכמים יותר: עיצוב מחדש של הזיכרון
מרכזי נתונים כיום מתמודדים עם אתגר גובר: שרתים מודרניים חייבים לנהל בו זמנית מספר רב של תוכניות עבור אלפי משתמשים, תוך שמירה על אבטחת...
פתרון חדש נגד חדירות סמויות לבקרי תעשייה
מערכת חדשה לזיהוי חדירות מציעה דרך יעילה יותר לאתר ולהתמודד עם איומי סייבר מתקדמים המכוונים לתשתיות קריטיות – כמו רשתות חשמל ומערכות מים. המערכת,...
רמקול חכם עם כוונון אוטומטי לחדר – עכשיו כאן
חברת WiiM הציגה את הרמקול החכם האלחוטי הראשון שלה, WiiM Sound, בתערוכת Munich High-End, וציינה בכך את כניסתה לשוק הסאונד הביתי. הרמקול משלב איכות...
הדור הבא של מטוסי קרב: אוטונומי, רב-תכליתי וללא מסלול המראה
פלטפורמת קרב בלתי מאוישת חדשה, בעלת יכולת המראה ונחיתה אנכית (VTOL), הוצגה לאחרונה, ומתוכננת לפעול מנמלים, איים ומיקומים צרים, תוך ביצוע מגוון משימות לחימה....
שילוב מדעי המוח והנדסה לפתרונות חדשניים לכאב
אוניברסיטת אוקספורד פתחה יוזמת מחקר שמטרתה לשנות את האופן שבו מטפלים בכאב כרוני. התוכנית, הממומנת על ידי מועצת המחקר למדעים פיזיים והנדסה (EPSRC), תתמקד...
הג׳ל המתכתי הראשון בעולם עשוי להניע את עתיד האנרגיה
צוות מחקר מאוניברסיטת טקסס A&M פיתח את הג׳ל המתכתי הראשון בעולם — סוג חדש של חומר המשלב את החוזק של מתכות עם הגמישות של...
סכנה למשתמשים: הדליפה שמזכירה לכולנו להחליף סיסמה
מאגר חדש של פרטי התחברות שנגנבו צץ ברשת, ובו נחשפו 183 מיליון כתובות אימייל וסיסמאות, שנוספו למאגר הפריצות של האתר “Have I Been Pwned”...
שידור רציף, גם על כנף מטוס: אנטנות גמישות בהדפסה תלת־ממדית
חוקרים מאוניברסיטת וושינגטון (WSU), בשיתוף עם אוניברסיטת מרילנד וחברת בואינג, פיתחו סוג חדש של אנטנות בהדפסה תלת־ממדית שעשוי לשנות את הדרך שבה כלי רכב,...
קפיצה בזיהוי חזותי: בינה מלאכותית לומדת להבחין בפריטים אישיים
מודלים של ראייה־שפתית (VLMs) הולכים ומשתפרים בזיהוי עצמים כלליים כמו "כלב" או "מכונית", אך הם עדיין מתקשים כאשר נדרש מהם להבחין בין פריטים דומים...
העתיד של השיקום הוויזואלי בעזרת בינה מלאכותית
דור חדש של טכנולוגיית ראייה מלאכותית מעניק לאנשים שאיבדו את ראייתם בעקבות מחלות הקשורות לגיל את היכולת לקרוא מחדש.
בניסוי קליני אירופאי, השתלת עין אלקטרונית...
פיתוח חדש מבטיח סוללות בטוחות יותר, עמידות וידידותיות לסביבה
חדשנות חומרית פורצת דרך עשויה לפתור אחת הבעיות העיקשות ביותר בטכנולוגיית הסוללות מהדור הבא. חוקרים פיתחו שכבת ביניים בעלת יכולת ריפוי עצמי, המשפרת משמעותית...
עם דיוק של 99%: כך חברת Never Mine מעצבת מחדש את...
Never Mine הינה בוגרת מרכז החדשנות INNOFENSE (אינופנס) שמפעילה iHLS בשיתוף עם משרד הביטחון. תוכנית האצה ייחודית זו מסירה עבור יזמים את החסמים לאקוסיסטם הטכנולוגי, והופכת...
שיטה חדשה לייצור מגנטים תחזק את מנועי האנרגיה הנקייה
צוות מחקר פיתח טכניקת ייצור מתקדמת למגנטים שיכולה לשפר את הביצועים והיעילות של מנועים חשמליים המשמשים בטכנולוגיות אנרגיה נקייה. השיטה החדשה משלבת הלחמת פלזמה...